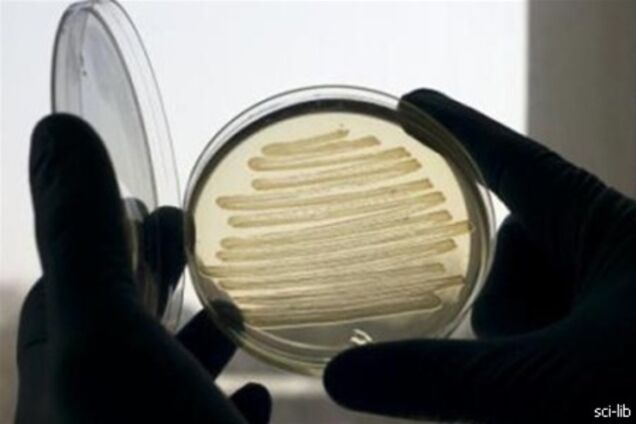
Ученые выяснили, как бактерии восстанавливают свою ДНК

Ученые выяснили, как бактерии восстанавливают свою ДНК
Микробиологи впервые смогли проследить за тем, как бактериальные клетки исправляют ошибки в своей ДНК, выяснив, что защитные системы бациллы находят поломку в геноме и исправляют ее за 2-2,5 секунды.
Все живые клетки содержат в себе особую белковую систему, главной задачей которой является починка ошибок в ДНК, которые появляются в ней в результате действия агрессивных соединений, радиации или "ошибок" во время деления клетки. Такие белки умеют находить "пробелы" в цепочке ДНК, "неправильные" буквы-нуклеотиды, исправлять их или инициировать систему самоуничтожения клетки, если ошибку нельзя исправить, пишет РИА Новости со ссылкой на статью в журнале Proceedings of the National Academy of Sciences
Группа биологов под руководством Стефана Апхоффа из Оксфордского университета (Великобритания) впервые смогла проследить за работой ее ключевых белков — ДНК-полимеразы и лигазы. Для этого ученые вставили в гены кишечной палочки, отвечающие за сборку этих белков, дополнительные "инструкции", заставлявшие клетки добавлять к ним дополнительные цепочки аминокислот, светящиеся при облучении лазером.
Вырастив колонию из таких микробов, биологи проследили за активностью этих белков при помощи фотолокализующего микроскопа (PALM). При наблюдении за клеткой PALM-микроскоп облучает ее лазерными импульсами, которые включают и выключают часть молекул пигмента. Фотодатчики фиксируют вылетевшие из клетки фотоны и "собирают" изображение клетки по нескольким тысячам вспышек.
По словам биологов, молекулы белков в клетках с исправной ДНК находятся в ее центре и двигаются беспорядочно. При повреждении генома их поведение меняется — белки начинают присоединяться к цепочкам ДНК и двигаться по их поверхности. В среднем, ошибки в геноме кишечной палочки исправлялись за 2-2,5 секунды благодаря большому количеству молекул белков. Как полагают авторы статьи, их методика и выводы могут использоваться при исследовании того, как возникают раковые клетки и как это можно предотвратить.










